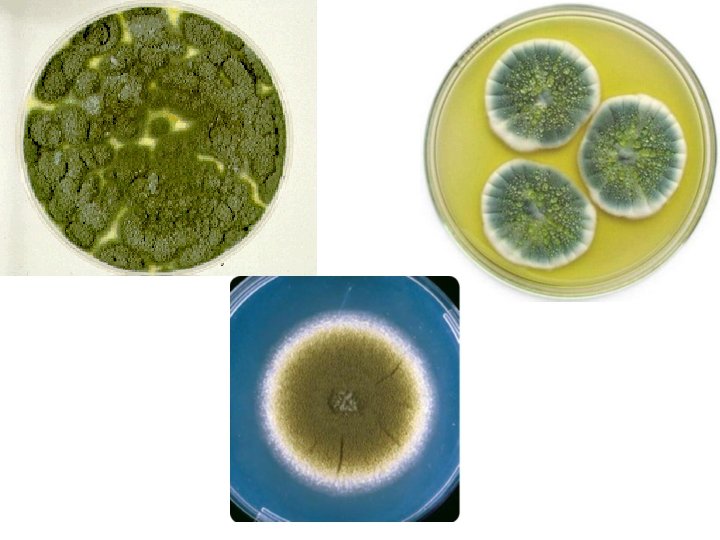
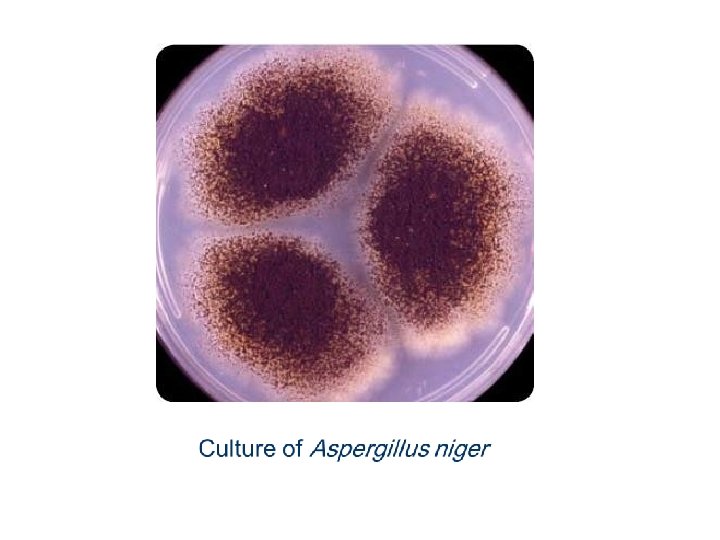
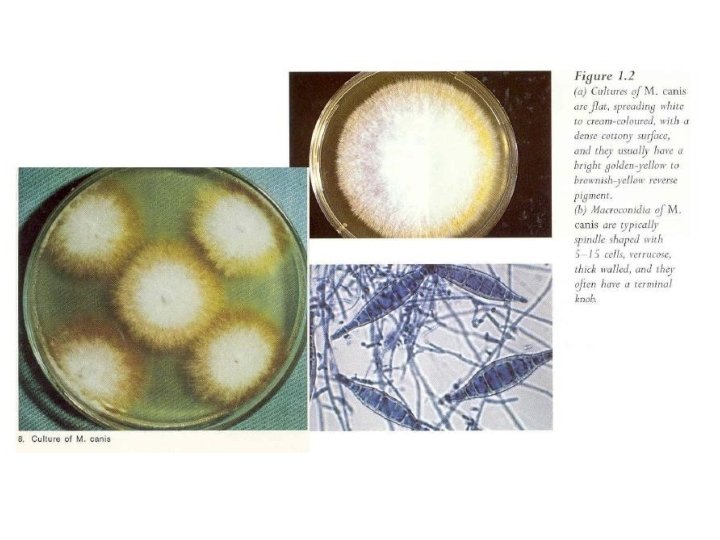

Practical medical mycology Lab 6 Identification of Fungal

ﺑﺴﻢ ﺍﻟﻠﻪ ﺍﻟﺮﺣﻤﻦ ﺍﻟﺮﺣﻴﻢ Practical medical mycology Lab 6 Identification of Fungal Isolates

Identification of Fungal Isolates The identification of Fungal Isolates is primarily based on: • Microscopic morphology. • Culture characteristics (morphological features), although less reliable, may also be useful. These include: – surface texture, –surface colour – pigmentation, – reverse pigmentation

Penicillium sp. • Colonies are usually fast growing, in shades of green, sometimes white, mostly consisting of a dense felt of conidiophores. • Microscopically, chains of single-celled conidia (ameroconidia) are produced in basipetal succession from a specialized conidiogenous cell called a phialide.

Conidia

Aspergillus sp. • Aspergillus colonies are usually fast growing, white, yellow-brown, brown to black or shades of green, and they mostly consist of a dense felt of erect conidiophores. • Conidiophores terminate in a vesicle covered with either a single palisade-like layer of phialides (uniseriate) or a layer of subtending cells (metulae) which bear small whorls of phialides (the so-called biseriate structure).


Aspergillus niger • Colonies consist of a compact white or yellow basal felt covered by a dense layer of dark-brown to black conidial heads. • Conidial heads are biseriate with the phialides borne on brown, often septate metulae.

Conidial head of A. niger Note: conidial heads are biseriate, large, globose, dark brown becoming radiate with the phialides borne on metulae ,

Identification of common dermatophytes • The identification of dermatophytes is primarily based on the microscopic morphology of the fungus. – A good slide preparation is required and in some strains sporulation stimulation may be required. – Culture characteristics, such as surface texture, topography and pigmentation, are variable and are therefore the least reliable criteria for identification.

Identification of common dermatophytes • Clinical information such as – the site, – appearance of the lesion, – geographic location, – travel history, – animal contacts and – race (strain) is also important,

Epidermophyton group • Key features include – characteristic greenish brown – The production of smooth, walled, club- shaped macroconidia thin-

Microsporum group • In this group it is essential to observe macroconidia to make the identification. • Microsporum canis • Key features include • distinctive spindle-shaped macroconidia, • culture characteristics (Figure), and • abundant growth and sporulation on polished rice grains and • in vitro perforation of hair.

Wood's lamp • It is used extensively to help diagnose fungal infections of the scalp. • The light causes hairs infected with a fungus such as Microsporum canis to become brilliantly fluorescent. • Principle: The rays from a quartz lamp pass through Wood's filter, which screens out visible UV rays and transmits longer invisible UV rays which upon contact with some chemicals cause a luminescence

Wood's lamp • About 50% of M. canis strains produce metabolites following hair invasion which fluoresce an apple-green colour when illuminated by the lamp. Such hairs are excellent specimens for microscopy and culture.

Microsporum nanum • Key features include – distinctive macroconidia and – culture characteristics (Figure)


Trichophyton group • Microconidia are more important and their shape, size and arrangement should be noted. Culture characteristics are also useful. • Common species include: • T. rubrum, • T. mentagrophytes and varieties, • T. tonsurans and T. equinum.

Trichophyton rubrum • Key features include: – culture characteristics, – microscopic morphology and – failure to perforate hair in vitro.


T. mentagrophytes • Key features include: • culture characteristics, microscopic morphology and clinical disease with known animal contacts (Figure 1. 8(a) and (b)).


T. verrucosum • Key features include: culture characteristics and requirements for thiamine and inositol, large ectothrix invasion of hair, clinical lesions and history.

- Slides: 26